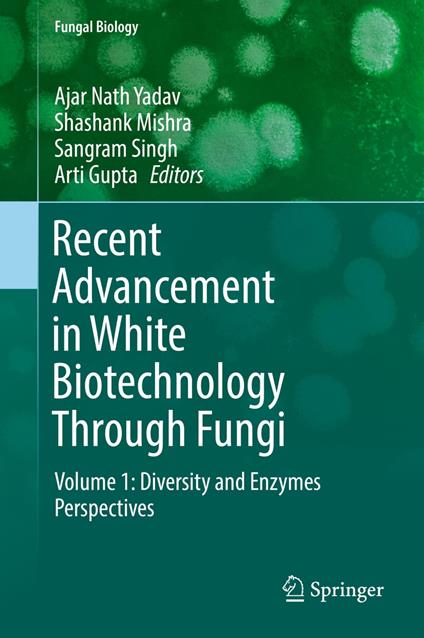
Recent Advancement in White Biotechnology Through Fungi

Recent Advancement in White Biotechnology Through Fungi
White biotechnology, or industrial biotechnology as it is also known, refers to the use of living cells and/or their enzymes to create industrial products that are more easily degradable, require less energy, create less waste during production and sometimes perform better than products created using traditional chemical processes. Over the last decade considerable progress has been made in white biotechnology research, and further major scientific and technological breakthroughs are expected in the future. Fungi are ubiquitous in nature and have been sorted out from different habitats, including extreme environments (high temperature, low temperature, salinity and pH), and may be associated with plants (epiphytic, endophytic and rhizospheric). The fungal strains are beneficial as well as harmful for human beings. The beneficial fungal strains may play important roles in the agricultural, industrial, and medical sectors. The fungalstrains and their products (enzymes, bioactive compounds, and secondary metabolites) are very useful for industry (e.g., the discovery of penicillin from Penicillium chrysogenum). This discovery was a milestone in the development of white biotechnology as the industrial production of penicillin and antibiotics using fungi moved industrial biotechnology into the modern era, transforming it into a global industrial technology. Since then, white biotechnology has steadily developed and now plays a key role in several industrial sectors, providing both high value nutraceutical and pharmaceutical products. The fungal strains and bioactive compounds also play an important role in environmental cleaning. This volume covers the latest developments and research in white biotechnology with a focus on diversity and enzymes.
-
Curatore:
-
Anno edizione:2019
-
Editore:
-
Formato:
Formato:
Gli eBook venduti da Feltrinelli.it sono in formato ePub e possono essere protetti da Adobe DRM. In caso di download di un file protetto da DRM si otterrà un file in formato .acs, (Adobe Content Server Message), che dovrà essere aperto tramite Adobe Digital Editions e autorizzato tramite un account Adobe, prima di poter essere letto su pc o trasferito su dispositivi compatibili.
Cloud:
Gli eBook venduti da Feltrinelli.it sono sincronizzati automaticamente su tutti i client di lettura Kobo successivamente all’acquisto. Grazie al Cloud Kobo i progressi di lettura, le note, le evidenziazioni vengono salvati e sincronizzati automaticamente su tutti i dispositivi e le APP di lettura Kobo utilizzati per la lettura.
Clicca qui per sapere come scaricare gli ebook utilizzando un pc con sistema operativo Windows